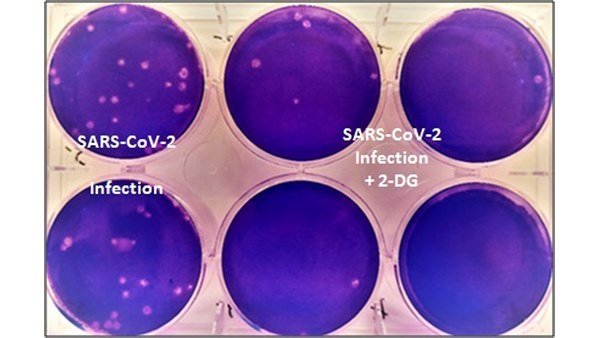

Dr. Reddy’s announces commercial launch of DRDO's 2-DG
New Delhi, June 28: Drugmaker Dr. Reddy's Laboratories has announced the commercial launch of 2-deoxy-D-glucose (2-DG), an oral drug, found to help speed up recovery and reduce oxygen dependence.
2-DG drugs clinical trial results have shown that this molecule helps in faster recovery of hospitalised patients and reduces supplemental oxygen dependence.
DRDO's 2-DG manufacturer
The oral drug has been developed by Institute of Nuclear Medicine and Allied Sciences (INMAS), a lab of Defence Research and Development Organisation (DRDO), in collaboration with Dr Reddy's Laboratories (DRL), Hyderabad.
DRDO anti-covid drug: Dosage and how it works
The drug comes in a powder form in a sachet and is taken orally by dissolving it in water. The drug accumulates in the virus-infected cells and prevents virus growth by stopping viral synthesis and energy production. The drug will stop the virus from multiplying.
DRDO anti-covid drug price and availability
The maximum retail price (MRP) of each sachet has been fixed at Rs. 990, with a subsidised rate offered to Government institutions. For now, the drug will available in hospitals across metros and Tier 1 cities, and subsequently expand coverage to the rest of India.
Will DRDO's 2DG medicine work against COVID variants?
According to the clinical trials, the drug is supposed to arrest any variant as a multiplying virus, irrespective of variant, will need food and thus will get trapped by the drug.
Will DRDO's 2-DG drug be a game changer?
DRDO's anti-covid drug is seen as a game changer as it helps in faster recovery of hospitalised patients and reduces supplemental oxygen dependence. "In 2-DG arm, significantly higher proportion of patients improved symptomatically and became free from supplemental oxygen dependence (42% vs 31%) by Day-3 in comparison to SoC, indicating an early relief from oxygen therapy/dependence. The similar trend was observed in patients aged more than 65 years," the DRDO said.
This comes as a boon amid the devastating second COVID-19 wave, where a large number of patients are facing severe oxygen dependency and need hospitalisation.
-
Pradeep Ranganathan's Chat With Actress Leaked Online Ahead of LIK Release? -
Dhurandhar 2 Box Office Collection Day 20: Ranveer Singh Film Holds Strong, Crosses ₹1,000 crore Net In India -
Stung! A Jolt To BJP Ahead Of West Bengal Polls? Kabir Fallout May Undo Minority Vote Split -
Trisha Married To Rich Businessman? Actress Shoots Down Rumours Amid Link-Up Speculations With Vijay -
IPL 2026: Gujarat Titans Captain Shubman Gill Fined Rs 12 lakh -
Is Raghav Chadha Planning To Build A New Party? Social Media Post Amid AAP Rift Triggers Speculation -
Jana Nayagan Leak: BJP, DMK Released Vijay's Film Online, Aadhav Arjuna's Big Claims -
Who Is Humayun Kabir? From Mamata’s Aide To Rival, Role In Babri Masjid Construction And Assets Revealed -
Delhi HC Slams Rana Ayyub's 'Ravana Didn't Touch Sita' Tweet, Remarks on Hindu Deities, Savarkar -
Gold Prices Slip Below ₹1.50 Lakh in India Ahead Of RBI MPC Announcement, Market Sees Rare Decoupling -
AIADMK Symbol Case: Sukesh Chandrasekhar Granted Bail by Delhi Court -
Tamil Nadu Polls: Who Is The Richest Candidate In 2026 Election? Leema Rose With Rs 5000 Crore












Click it and Unblock the Notifications